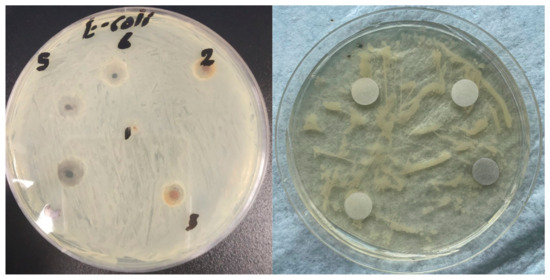

Abstract
Eco-friendly iron and manganese oxide nanoparticles (Fe2O3 and Mn2O3) were synthesized and integrated into graphene sheets to form uniform composites. These composites were then embedded in polyvinyl alcohol (PVA) fibers using electrospinning. Comprehensive characterization of the composites and the final composite fibers was conducted using XRD, FE-SEM, and FTIR to analyze their structural complexity and morphological differences. The antibacterial efficacy of the resulting PVA nanofibers was evaluated against Escherichia coli, which is a common pathogen in hospital environments. The results show a significant bactericidal effect against these bacteria, which highlights their potential in medical applications, such as functional bandages and wound dressings. This study paves the way for potential commercial applications of these nanofibers in healthcare settings.
1. Introduction
Reducing dimension and size generally has a strong impact on the surface area and loading capacity of materials, which opens many frontiers in terms of applications [1]. One-directional (1D) growth has the capability of not only revolutionizing the methods of synthesis and preparation of new materials but has also the potential of revealing and capitalizing on unique emergent properties. These properties bring about tunable functionalities and advances that open up diverse technological applications [2]. Among the preparation methods that generate 1D nanostructured fibers with nano-size thickness, electrospinning is one of the most popular techniques due to its versatility and adaptation to match specific properties in the end products. In this regard, electrospinning can generate polymer-based nanostructured material scaffolds with macroscopic lengths [3,4]. Specifically, the method can integrate hydrophilic polymer-based materials that have applications in the medical and allied health fields. Fiber-forming hydrophilic polymers are often targeted in medical applications due to their established biocompatibility, chemical and physical shielding, and suitable long-term biodegradability [5,6]. Scaffolds based on polyvinyl alcohol (PVA) have been used in a variety of medical settings due to their adaptive tensile and swelling properties, relatively light weights, and suitable biodegradation kinetics.
Electrospinning has also opened the field for the preparation of hybrid materials made of polymers such as PVA combined with other dimensionally structured materials with unique properties and many lines of applications [7,8]. The added materials impart new properties to the final nanostructured scaffold. For instance, the inclusion of silver nanoparticles or other inorganic metal oxide nanoparticles, such as copper oxide and zinc oxide, brought about emergent antibacterial properties in the final electrospun PVA composite nanomaterials. The relatively high loading of added metal oxide nanoparticles in one-dimensional PVA nanofibers generates unusual regenerative features and unique properties that enhance the performance of the composite materials in biomedical applications, such as the case of functional wound dressings [9,10,11].
The integration of reduced graphene oxide (rGO) into polyvinyl alcohol (PVA) formulations presents a multitude of advantages. Specifically, it has the potential to enhance the mechanical, electrical, and thermal properties of polymer nanocomposites. The unique characteristics of rGO, such as its high surface area and excellent electrical conductivity, facilitate significant improvements in the overall performance of PVA-based materials [12].
One of the primary benefits derived from rGO/PVA formulations is the enhancement of mechanical strength. The incorporation of rGO leads to a notable increase in tensile strength and elasticity due to the formation of a stronger network within the polymer matrix. This occurs through effective interactions between rGO and PVA, which promote cross-linking and hydrogen bonding, thereby reducing free volume and enhancing structural integrity [13]. The mechanical properties are further complemented by improved thermal stability, as rGO enhances the thermal conductivity of the composite, making it suitable for applications requiring heat resistance. The presence of rGO also significantly increases the conductivity of PVA composites. As the concentration of rGO increases, a percolation threshold is reached at which conductive pathways form throughout the matrix, allowing for enhanced charge transport. This phenomenon is crucial for applications in sensors and electronic devices in which efficient conductivity is essential [13]. Studies have demonstrated that these composites exhibit a linear relationship between rGO content and electrical conductivity, underscoring their potential for use in flexible electronics and energy storage systems [14].
Moreover, the biocompatibility of rGO/PVA composites makes them particularly advantageous for biomedical applications. The inherent properties of rGO facilitate cell adhesion and proliferation, which are essential for tissue engineering scaffolds and wound-healing applications. The ability to modulate reactive oxygen species (ROS) levels through controlled rGO concentrations further enhances their angiogenic properties, thereby promoting vascularization in regenerative medicine [15].
Finally, the incorporation of rGO into PVA matrices has shown promise in environmental applications. These composites can effectively adsorb heavy metals and pollutants from water due to their high surface area and functional groups that enhance adsorption capacities. This capability positions rGO/PVA formulations as effective materials for water purification technologies [16].
Other metal oxide nanoparticles have been explored as functional additives within PVA nanofibers because of their promising properties [17]. Of particular interest, manganese (Mn) and iron (Fe) oxides are gaining more attention due to their antibacterial properties and good safety profiles [11,18,19,20]. The intrinsic high surface area per volume unit of the composite metal oxide/PVA nanofibers drives higher antimicrobial efficacy than traditional PVA micro-fibers [21]. PVA nanofibers decorated with metal oxide nanostructures are generally more active than unmodified PVA materials [22,23].
Graphene oxide (GO), as a two-dimensional (2D) component, has been shown to exhibit antibacterial activity. It was also used to enhance the robustness of the electrospun PVA nanofiber network. This work combines metal oxides with reduced graphene oxide as a nanocomposite embedded into PVA nanofibers prepared in a one-pot electrospinning process. We use well-established synthesis and characterization protocols to determine whether the three-component (Fe2O3-rGO-PVA or Mn2O3-rGO-PVA) nanocomposite materials exhibit synergistic antibacterial effects that exceed the performance of individual components.
2. Materials and Methods
2.1. Chemicals and Reagents
All chemicals were used as received without further purification. Manganese (II) acetate tetrahydrate (Acros Organics, Geel, Belgium, >99%), iron(III) chloride anhydrous (98%, Fisher Scientific, Pittsburgh, PA, USA), citric acid anhydrous (Fisher Scientific, 99.5%), ammonia solution (Fisher Scientific, 35%), sodium hydroxide (Fisher Scientific, ≥97%), potassium permanganate (KMnO4, Alfa Aesar, 98%, Karlsruhe, Germany), polyvinyl alcohol (PVA, Sigma-Aldrich, 86–89% hydrolyzed, high molecular weight (80,000–120,000)), and graphite powder (Sigma-Aldrich, Taufkirchen, Germany) were used. Sulfuric acid (H2SO4, 98%), hydrochloric acid (HCl, 33%), and hydrogen peroxide (H2O2, 30%) were used as received. Deionized Milli-Q water was employed throughout the experimental procedures.
2.2. Synthesis of Graphene Oxide Sheets
Graphene oxide was prepared using the well-established modified Hummers method [24,25,26]. Briefly, 1 g of graphite powder was combined with 35 mL of sulfuric acid (H2SO4) and 3 g of potassium permanganate (KMnO4). This mixture was stirred for an hour in an ice water bath to maintain a temperature below ambient levels. The gradual addition of 120 mL of 30% hydrogen peroxide (H2O2) was performed while stirring and heating the mixture to 100 °C for an hour. The suspension was then diluted with 280 mL of distilled water. The resulting GO was thoroughly washed with 2 M hydrochloric acid (HCl) and then with deionized water. The solid was subsequently dried at 100 °C overnight. This procedure consistently yielded high-quality GO suitable for the follow-up steps of this work, yielding 0.8 g of GO, with a percent yield of 80%.
2.3. Synthesis of Mn2O3 Nanoparticles
The synthesis of Mn2O3 nanoparticles (NPs) was carried out using a refined hydrothermal method. Briefly, an aqueous citric acid solution (20 mmol in 50 mL deionized water) was incrementally mixed with a solution of manganese (II) acetate tetrahydrate (30 mmol in 50 mL deionized water) and stirred continuously for 15 min. The pH of this mixture was adjusted to approximately 10 using a 5 M NaOH solution. This resulting solution was then transferred to a 150 mL Teflon-lined stainless steel autoclave and subjected to a temperature of 180 °C for 2 h. Post-cooling, the resulting precipitate was separated via centrifugation at 8000 rpm, thoroughly rinsed with deionized water, oven-dried overnight at 80 °C, and calcined at 550 °C for 2 h yielding 1.87 g of Mn2O3 NPs, percent yield 78.90%.
2.4. Synthesis of Fe2O3 Nanoparticles
Fe2O3 nanoparticles were synthesized using a co-precipitation approach. Typically, a 1 M FeCl3 solution in deionized water (100 mL) is heated to 80 °C. Subsequently, 25% ammonia solution is gradually added under continuous stirring for two hours. The resulting precipitate is separated using centrifugation at 8000 rpm, followed by repeated washing with deionized water. The washed precipitate was then dried at 80 °C overnight and subjected to calcination at 400 °C for four hours to obtain the final Fe2O3 nanoparticles of approximately 7.08 g, with a percent yield of 88.72% [27].
2.5. Synthesis of Mn2O3-rGO and Fe2O3-rGO Nanocomposites
The synthesis of Mn2O3-reduced graphene oxide (rGO) nanocomposites was achieved using three distinct Mn2O3-to-GO weight ratios: 2:1, 3:1, and 4:1. This process involved blending Mn2O3 with GO in a 100 mL deionized water medium. Subsequently, the mixture was subject to sonication for 15 min at a power setting of 600 Watts, which finally yielded the desired Mn2O3-rGO nanocomposite with the various ratios [28]. The synthesis of Fe2O3-rGO nanocomposites followed the same process described above for Mn2O3-rGO.
2.6. Preparation of Mn2O3-rGO and Fe2O3-rGO PVA Nanofibers
The Mn2O3-rGO and Fe2O3-rGO nanocomposites, which were formulated in ratios of 2:1, 3:1, and 4:1, were independently incorporated into a 10% (w/v) PVA solution at a 10% (wt./wt.) ratio. This mixture was stirred continuously for 3 h at 50 °C to achieve homogeneity. The mixture was then subjected to room-temperature electrospinning in a NANON-01A electro-spinner (MECC CO., LTD, Fukuoka, Japan). Briefly, the mixture was transferred into a 5 mL syringe (22 G). The needle tip is set at a 15 cm distance from the collector. A high voltage of 30 kV was then applied with a flow rate set at 0.3 mL/h. The nanofibers collected on aluminum foil in the electrospinning chamber underwent heat treatment at 80 °C for 12 h. The fiber yield by mass was approximately 0.44 g, with a percentage yield of around 80%.
2.7. AntiMicrobial Activity Study
Circular samples of the two composites (Fe2O3-rGO and Mn2O3-rGO) embedded in PVA fibers, each 1 mm in diameter and of uniform thickness, were prepared in varying concentrations (2:1, 3:1, and 4:1). These samples were subjected to the disk diffusion assay (Kirby–Bauer disk method) to assess their antibacterial activity against Gram-negative bacteria, Escherichia coli. The test involved placing the samples on agar plates that were inoculated with these microorganisms and uniformly swabbed. The inhibition zones around the disks were measured at 37 °C to evaluate the antibacterial effectiveness of the composites [7,29].
2.8. Characterization Techniques
The characterization of the synthesized samples involved X-ray diffraction (XRD) using a Malvern Panalytical Empyrean 3 diffractometer, which was aimed at identifying their phase composition and crystalline structure. Fourier-transform infrared spectroscopy (FTIR) analyses were conducted with a Vertex 70 FTIR spectrometer, capturing spectra across a range of 4000–400 cm−1 at a resolution of 4 cm−1. The morphology and particle size were examined using a Quattro S Field-emission Scanning Electron Microscope (FESEM) from Thermo Scientific, Waltham, MA, USA.
3. Results and Discussion
3.1. XRD Characterization
Figure 1A shows XRD patterns of the as-prepared Mn2O3 and Mn2O3-rGO nanocomposites with Mn2O3-to-rGO ratios of (2:1), (3:1), and (4:1), respectively, as well as electrospun Mn2O3-rGO-PVA nanofibers with the same Mn2O3-to-rGO ratios. The pattern profiles indicated the six characteristic diffraction peaks of the cubic Mn2O3 phase, with reference code JCPDS No. 041–1441 observed at 27.5°, 31.6°, 45.4°, 56.5°, 66.1°, and 75.1°, which are assigned to the following planes, respectively: (122), (222), (323), (334), (622), and (264) [30,31]. XRD patterns of Mn2O3-rGO of ratios (2:1), (3:1), and (4:1), as well as the electrospun Mn2O3-rGO-PVA nanofibers, have the same characteristic diffraction peaks of the cubic Mn2O3 phase, but the electrospun Mn2O3-rGO-PVA nanofibers have lower intensities and a new diffraction peak at 19.58°, which assigned to the (101) reflection plane of PVA. This peak is suggested to be the host matrix for the Mn2O3-rGO nanocomposites, which is similar to the PVA reference code JCPDS No. 064–1617. Due to the small amount of rGO in the final matrix, their diffraction intensities are weak, resulting in very weak diffraction peaks in the XRD pattern. In addition, the inclusion and contribution of rGO might lead to a decrease in peak intensity and peak widening.

Figure 1.
(A). XRD of (a) Mn2O3, (b) Mn2O3-rGO (2:1), (c) Mn2O3-rGO (3:1), (d) Mn2O3-rGO (4:1), (e) Mn2O3-rGO (2:1)-PVA nanofiber, (f) Mn2O3-rGO (3:1)-PVA nanofiber, and (g) Mn2O3-rGO (4:1)-PVA nanofiber; (B). XRD of (a) Fe2O3, (b) Fe2O3-rGO (2:1), (c) Fe2O3-rGO (3:1), (d) Fe2O3-rGO (4:1), (e) Fe2O3-rGO (2:1)-PVA nanofiber, (f) Fe2O3-rGO (3:1)-PVA nanofiber, and (g) Fe2O3-rGO (4:1)-PVA nanofiber.
Figure 1B displays the XRD patterns of the as-prepared Fe2O3 and Fe2O3-rGO nanocomposites, as well as electrospun Fe2O3-rGO-PVA nanofibers. The pattern profiles indicate the seven characteristic diffraction peaks of the rhombohedral Fe2O3 phase (space group: R-3c) with reference code JCPDS No. 01-076-8394 observed at 24.13°, 33.15°, 35.62°, 40.86°, 49.45°, 54.06° and 57.59°, which are assigned to the following planes (012), (104), (110), (113), (024), (116), and (018), respectively. The different crystalline phases of Fe2O3 can be distinguished based on their unique diffraction patterns of iron oxide nanoparticles. Fe2O3 can typically be identified as (α-Fe2O3), which is the most common phase, also known as hematite. It has a rhombohedral crystal structure, and its diffraction peaks are sharp and strong. Hematite typically shows characteristic peaks at 2θ values around 24.1° to 64° [32,33]. By combining the XRD results with FTIR analysis, we can confirm the crystalline phase of Fe2O3 in our samples. These complementary techniques ensure that both the crystal structure and bonding environment are consistent with α-Fe2O3 [32]. XRD patterns of Fe2O3-rGO of weight ratios (2:1), (3:1), and (4:1), as well as the electrospun Fe2O3-rGO-PVA nanofibers, are also shown. They have the same characteristic diffraction peaks of the cubic Mn2O3 phase. However, the XRD patterns of electrospun Fe2O3-rGO-PVA nanofibers have lower intensities than those of Mn2O3-rGO-PVA, with a new diffraction peak at 19.58° matching the (101) reflection plane of PVA as the host matrix for the Fe2O3-rGO nanocomposites. The peak corresponds to that of the PVA reference code JCPDS No. 064–1617. Like the case of iron oxide, the diffraction intensities of rGO are very weak, which causes the diffraction peaks in the XRD pattern to be obscured by other high-intensity peaks, such as those of Mn2O3-rGO-PVA.
3.2. FT-IR
Figure 2A,B illustrates the FTIR spectra of Mn2O3 nanoparticles, Mn2O3-rGO nanocomposites at various weight ratios (2:1, 3:1, and 4:1), and Mn2O3-rGO-PVA nanofibers. The key vibrational bands observed in the Mn2O spectra correspond to Mn–O stretching vibrations at 554 cm−1, 482 cm−1, and 443 cm−1, indicating the characteristic modes of Mn2O3. Upon integrating rGO into the nanocomposite, distinct bands attributed to rGO appear, such as the 1600 cm−1 (C=C stretching) and 1014 cm−1 (C-O alkoxide) bands. Importantly, the intensity of these bands increases with a higher rGO content, suggesting stronger π–π stacking interactions and charge transfer between rGO sheets and Mn2O3 nanoparticles. This band intensity change provides evidence of the interaction between Mn2O3 and rGO, likely through electrostatic or van der Waals forces.

Figure 2.
(A,B) Spectra for two windows of wavenumbers: FTIR spectra of (a) Mn2O3, (b) Mn2O3-rGO (2:1), (c) Mn2O3-rGO (3:1), (d) Mn2O3-rGO (4:1), (e) Mn2O3-rGO (2:1)-PVA nanofiber, (f) Mn2O3-rGO (3:1)-PVA nanofiber, and (g) Mn2O3-rGO (4:1)-PVA nanofiber; (C,D) spectra for two windows of wavenumbers: FTIR spectra of (a) Fe2O3, (b) Fe2O3-rGO (2:1), (c) Fe2O3-rGO (3:1), (d) Fe2O3-rGO (4:1), (e) Fe2O3-rGO (2:1)-PVA nanofiber, (f) Fe2O3-rGO (3:1)-PVA nanofiber, and (g) Fe2O3-rGO (4:1)-PVA nanofiber.
The incorporation of Mn2O3-rGO into the electrospun PVA nanofibers is confirmed by the persistence of Mn2O3-rGO-specific bands in the FTIR spectrum of the composite nanofibers. The characteristic PVA bands observed at 3325 cm−1 (O-H stretching), 1430 cm−1 (C–OH stretching), and 1088 cm−1 (C-O stretching) further confirm the successful integration of Mn2O3-rGO into the PVA matrix without significant alteration of its structural integrity.
In Figure 2C,D, the FTIR spectra of Fe2O3 nanoparticles, Fe2O3-rGO nanocomposites, and Fe2O3-rGO-PVA nanofibers shed light on the interaction between Fe2O3 and rGO. The Fe2O3 nanoparticles exhibit a sharp band around 550–570 cm−1, corresponding to Fe–O stretching in α-Fe2O3. This band remains prominent in the Fe2O3-rGO composite, indicating that the Fe2O3 structure is retained even after embedding with rGO. Furthermore, the appearance of bands at 520 cm−1 and 436 cm−1 in the composite also points to Fe–O stretching modes, suggesting the physical interaction between Fe2O3 and rGO and confirming the hematite rhombohedral crystal structure of α-Fe2O3, as indicated by XRD [32,33].
The C=C stretching band of rGO observed at 1614 cm−1 shows an increase in intensity with increasing rGO concentration, indicating stronger interactions within the composite. These interactions likely arise from charge transfer between Fe(III) ions and the conjugated π-electron system of rGO, which affects the local electronic environment of rGO and enhances the composite’s overall stability.
When Fe2O3-rGO is incorporated into PVA nanofibers, the FTIR spectra confirm the presence of both Fe2O3 and rGO bands, further validating the integration of Fe2O3-rGO into the electrospun fibers. Similar to the Mn2O3 system, the PVA characteristic bands are observed at 3325 cm−1, 1438 cm−1, and 1088 cm−1, corresponding to the hydroxyl (O-H) group and C–OH stretching vibration, as well as the C-O stretching mode. The shifts and intensity changes in the FTIR spectra, particularly the C=C band for rGO and Fe–O/Mn–O bands for the metal oxides, indicate a strong interaction between the metal oxide nanoparticles (Mn2O3 and Fe2O3) and rGO. This interaction is likely a combination of electrostatic attraction and π–π stacking, with additional contributions from van der Waals forces. The successful integration of the nanocomposite within the PVA nanofibers is supported by the preservation of both metal oxide and rGO spectral features, which confirm that no significant chemical bonding disruption occurs upon electrospinning.
The morphologies of the Mn2O3 and Fe2O3 nanoparticles embedded with GO at ratios of (2:1), (3:1), and (4:1), as well as their corresponding electrospun PVA nanofibers, were examined using FESEM. Figure 3 shows the morphological structures of electrospun Fe2O3-rGO/PVA nanofibers with the various iron oxide to graphene oxide weight ratios [Fe2O3-to-GO ratios of (2:1), (3:1), and (4:1), respectively]. The SEM micrographs show that the Fe2O3-rGO nanocomposites are dispersed on the PVA nanofiber surfaces, which imparts nanosized roughness commensurate with the size and number of the metal oxide nanoparticles embedded. This reveals that the as-prepared Fe2O3 nanoparticles are uniformly dispersed across the rGO surface, with an average size of 40 nm. Such uniform dispersion can be attributed to the electrospinning method used during synthesis, which aids in controlling the particle size distribution and minimizing agglomeration. Similar studies on Fe2O3 nanofibers have demonstrated that uniform size distribution is crucial for enhanced performance in various applications. For instance, Nalbandian et al. synthesized Fe2O3 nanofibers with diameters ranging from 23 nm to 63 nm and noted that smaller diameters improved surface area and adsorption properties [34]. In our case, the tightly anchored Fe2O3 nanoparticles on the rGO nanosheets maintain a well-distributed morphology, likely contributing to improved surface interactions for catalytic and adsorption applications. The added rGO nanosheets improve the nanocomposite’s robustness and mechanical properties. The wrinkled morphology of the rGO seems to prevent the typical hydrophobic stacking of the sheets and therefore counteracts aggregation. This feature imparts added thermodynamic stability to the nanocomposite.

Figure 3.
SEM images of (a) Fe2O3-rGO (2:1), (b) Fe2O3-rGO (3:1), (c) Fe2O3-rGO (4:1), (d) Fe2O3-rGO (2:1)-PVA nanofiber, (e) Fe2O3-rGO (3:1)-PVA nanofiber, and (f) Fe2O3-rGO (4:1)-PVA nanofiber. (g) Fiber diameter distribution of Fe2O3-rGO (2:1); (h) fiber diameter distribution of Fe2O3-rGO (3:1); and (i) fiber diameter distribution of Fe2O3-rGO (4:1).
Figure 4 shows the as-prepared Mn2O3 nanoparticles as distributed features attached to the wrinkled rGO surface. In contrast, the Mn2O3 nanoparticles are more heterogeneously distributed, with an average size of ~70 nm. This size is larger compared to the Fe2O3 particles, which might be due to differences in the synthesis mechanism and the intrinsic properties of Mn2O3. Berenjian et al. described Mn2O3 nanofibers with a mesoporous structure and noted that variations in pore sizes and particle distribution are common depending on the synthesis method [35]. The larger size of Mn2O3 in this study may also be influenced by the growth conditions during the attachment process onto the rGO nanosheets, in which the increased surface roughness of the nanosheets could have facilitated the nucleation and growth of larger Mn2O3 particles; it may also be the result of the aggregation of smaller particles. Similar to the case of Fe2O3, the wrinkled morphology of the Mn2O3-modified rGO nanosheets seems to enhance the mechanical strength of the PVA nanofiber and, at the same, time prevent aggregation, which should sustain the high surface-to-volume area of the nanomaterial. The overall structure of the electrospun Mn2O3-rGO/PVA nanofibers is similar to that of the case with Fe2O3, except that the size of the manganese oxide nanoparticles is relatively larger, as shown in Figure 4d–f.

Figure 4.
SEM images of (a) Mn2O3-rGO (2:1), (b) Mn2O3-rGO (3:1), (c) Mn2O3-rGO (4:1), (d) Mn2O3-rGO (2:1)-PVA nanofiber, (e) Mn2O3-rGO (3:1)-PVA nanofiber, and (f) Mn2O3-rGO (4:1)-PVA nanofiber, (g) Fiber diameter distribution of Mn2O3-rGO (2:1); (h) fiber diameter distribution of Mn2O3-rGO (3:1); and (i) fiber diameter distribution of Mn2O3-rGO (4:1).
3.3. Antimicrobial Activity
This study examines the antibacterial activity of the prepared PVA nanofibers against Escherichia coli, Gram-negative bacteria. Escherichia coli is often used as a model organism in antimicrobial studies due to its well-characterized genetics, ease of cultivation, and relevance as a common pathogen in healthcare settings. The Escherichia coli model aids in the understanding of the potential efficacy of antimicrobial agents against a broad spectrum of Gram-negative bacteria, which is critical for the development of treatments and preventive measures in clinical environments.
The disk diffusion method, also known as the Kirby–Bauer test, is a standard technique used to evaluate the antimicrobial properties of the prepared nanofibers against strands of Escherichia coli. Disks of nanofibers approximately 6 mm in size were placed into a Petri dish of Escherichia coli cell culture grown on agar. Measuring the zone of inhibition in millimeters provides a visual representation of antibacterial activity [6,36].
The investigation revealed that the Fe2O3-rGO/PVA nanofiber composites with metal oxide to graphene oxide weight ratios from 2:1 to 3:1 demonstrated increasing antibacterial properties, as shown by the increasing disk sizes in Figure 5 and as listed in Table 1. However, higher weight ratios did not result in higher antibacterial activity. In contrast, the antibacterial effect of Mn2O3-rGO/PVA nanofibers remained relatively constant across all different composite ratios. These preliminary findings suggest the potential application of these nanofibers as active ingredients in antimicrobial dressings, including wound-healing bandages [36,37]. Our results point to an optimum composite weight ratio of 3:1.
Figure 5.
Antibacterial assay results show the zones of inhibition for Fe2O3-rGO/PVA and Mn2O3-rGO/PVA nanocomposite fibers against Escherichia coli. The + dish demonstrates the effectiveness of various sample compositions in inhibiting bacterial growth, as indicated by the clear zones around the disks.

Table 1.
Inhibition zones measured in millimeters (mm) for Fe2O3-rGO/PVA and Mn2O3-rGO/PVA nanocomposite fibers at different composite ratios, demonstrating their antibacterial activity against Escherichia coli using the disk diffusion technique.
Metal oxides, like Fe2O3 and Mn2O3, are known for their antibacterial properties, primarily due to their ability to generate reactive oxygen species (ROS) and disrupt bacterial cell membranes. Fe2O3, in particular, has demonstrated enhanced ROS generation in the presence of GO, likely leading to higher oxidative stress in bacterial cells. This ROS production can damage bacterial membranes, proteins, and DNA, ultimately leading to bacterial cell death. The increasing antibacterial efficiency of Fe2O3-rGO/PVA composites from a 2:1 to a 3:1 weight ratio initially suggests that higher levels of Fe2O3 would result in increased ROS generation and thus higher antibacterial activity. However, higher levels of embedded iron oxide do not result in increased E. Coli killing. The activity plateau after the 2:1 weight ratio is possibly due to a saturation effect, in which further increases in Fe2O3 no longer result in increased ROS generation and antibacterial activity [38,39,40,41].
In contrast, the Mn2O3-rGO/PVA nanofibers exhibited consistent antibacterial performance across all composite ratios. This suggests that the antimicrobial mechanism of Mn2O3 may be less dependent on its concentration or that it reaches an effective threshold at lower concentrations. Mn2O3 is known for its ability to interact with microbial membranes and induce membrane depolarization, but it may not be involved in the production of ROS levels as high as those of Fe2O3. This could explain the lack of increasing activity with increasing Mn2O3 content.
The particle size of our nanofibers plays a crucial role in determining their antimicrobial activity, as it influences factors such as surface area, reactivity, and interaction with bacterial cells. In the case of the two composites studied, Fe2O3-rGO/PVA nanofibers have a particle size of approximately ~40 nm, while Mn2O3-rGO/PVA nanofibers possess a larger particle size of around ~70 nm. This difference in particle size may play a role in observed differences in their respective antimicrobial activities.
The Fe2O3 nanoparticles with smaller sizes present a larger surface area-to-volume ratio compared to the larger Mn2O3 particles. This higher surface area allows for increased interaction with bacterial membranes, which is a key mechanism in the antimicrobial action of nanomaterials. The smaller Fe2O3 particles are more efficient at generating reactive oxygen species (ROS), which can cause oxidative stress and damage to bacterial cells. Additionally, their smaller size allows for better dispersion within the composite, preventing aggregation and maintaining the composite’s structural integrity. The smaller particle size within Fe2O3-rGO/PVA nanofibers and the underlying higher dispersion of Fe2O3 in the PVA matrix both explain the increasing antibacterial activity with increasing amounts of Fe2O3 up to the level of saturation of the optimal 3:1 weight ratio of Fe2O3 to rGO.
Conversely, the Mn2O3 nanoparticles, with a larger particle size of 70 nm, offer a lower surface area-to-volume ratio. This reduction in surface area can limit their interaction with bacterial cells and the generation of ROS, leading to a less pronounced antimicrobial effect than the smaller Fe2O3 particles. The larger Mn2O3 particles may also exhibit a tendency to aggregate more easily, further reducing their antimicrobial efficacy by decreasing the effective surface area available for interaction with bacteria. This could explain why the antimicrobial activity of Mn2O3-rGO/PVA composites remains constant across different weight ratios.
This preliminary evaluation of the antibacterial activity of these composite nanofibers not only highlights their potential in antimicrobial applications but also contributes to the broader understanding of how the rational bottom-up functionalization of electrospun fiber materials may result in efficient dressings that prevent bacterial infections.
4. Conclusions
Fe2O3 and Mn2O3 nanoparticles were synthesized using well-established co-precipitation and hydrothermal methods, respectively. They were then loaded into 2D reduced graphene via the probe sonication method, which resulted in well-stacked metal oxide graphene composites. Mn2O3- and Fe2O3-rGO nanocomposites were embedded into PVA nanofibers using an electrospinning technique. The FE-SEM images revealed that the nanocomposites are dispersed into the PVA nanofiber matrix. Electrospun Mn2O3-rGO/PVA nanofibers with Mn2O3-to-rGO ratios of (2:1), (3:1), and (4:1) showed average diameters of 327 nm, 434 nm, and 345 nm, respectively; Fe2O3-rGO-PVA nanofibers with ratios of (2:1), (3:1), (4:1) of Fe2O3 to rGO have average diameters of 198 nm, 302 nm, and 155 nm, respectively. The antibacterial activities of (Fe2O3-rGO) and (Mn2O3-rGO)/PVA nanofibers against various pathogenic growths were investigated and showed an inhibition of the most common negative bacteria (E. coli). These promising data show that our electrospun PVA nanofibers with embedded metal oxides have the potential to be used in medical applications, such as wound-healing materials and protective coatings.
Author Contributions
Conceptualization, M.B. and M.A.I.; methodology, H.K., I.G., A.I.A.-S., M.B. and M.A.I.; software, H.K. and I.G.;formal analysis, I.G., H.K., A.I.A.-S., M.B. and M.A.I.; investigation, I.G. and H.K.; resources, M.B. and M.A.I.; data curation, H.K., I.G., M.B. and M.A.I.; writing—original draft preparation, I.G. and H.K.; writing—review and editing, M.B. and M.A.I.; visualization, H.K. and I.G.; supervision, M.B. and M.A.I.; project administration, M.B. and M.A.I.; funding acquisition, M.B. and M.A.I.; All authors have read and agreed to the published version of the manuscript.
Funding
MB recognizes partial funding research from Cleveland State University and NIH (1R15GM140405-01A1).
Data Availability Statement
Most data is contained within the article. Other dataset available on request from authors.
Conflicts of Interest
The authors declare that they have no conflicts of interest.
References
- Biener, J.; Wittstock, A.; Baumann, T.F.; Weissmüller, J.; Bäumer, M.; Hamza, A.V. Surface chemistry in nanoscale materials. Materials 2009, 2, 2404–2428. [Google Scholar] [CrossRef]
- Reddy, V.S.; Tian, Y.; Zhang, C.; Ye, Z.; Roy, K.; Chinnappan, A.; Ramakrishna, S.; Liu, W.; Ghosh, R. A review on electrospun nanofibers based advanced applications: From health care to energy devices. Polymers 2021, 13, 3746. [Google Scholar] [CrossRef] [PubMed]
- Nadaf, A.; Gupta, A.; Hasan, N.; Ahmad, S.; Kesharwani, P.; Ahmad, F.J. Recent update on electrospinning and electrospun nanofibers: Current trends and their applications. RSC Adv. 2022, 12, 23808–23828. [Google Scholar] [CrossRef] [PubMed]
- Medeiros, G.B.; Lima, F.d.A.; de Almeida, D.S.; Guerra, V.G.; Aguiar, M.L. Modification and functionalization of fibers formed by electrospinning: A review. Membranes 2022, 12, 861. [Google Scholar] [CrossRef]
- He, S.; Wang, J.; Yu, M.; Xue, Y.; Hu, J.; Lin, J. Structure and mechanical performance of poly (vinyl alcohol) nanocomposite by incorporating graphitic carbon nitride nanosheets. Polymers 2019, 11, 610. [Google Scholar] [CrossRef]
- Nasrallah, D.A.; Ibrahim, M.A. Enhancement of physico-chemical, optical, dielectric and antimicrobial properties of polyvinyl alcohol/carboxymethyl cellulose blend films by addition of silver doped hydroxyapatite nanoparticles. J. Polym. Res. 2022, 29, 86. [Google Scholar] [CrossRef]
- Anstey, A.; Chang, E.; Kim, E.S.; Rizvi, A.; Kakroodi, A.R.; Park, C.B.; Lee, P.C. Nanofibrillated polymer systems: Design, application, and current state of the art. Prog. Polym. Sci. 2021, 113, 101346. [Google Scholar] [CrossRef]
- Nayl, A.A.; Abd-Elhamid, A.I.; Awwad, N.S.; Abdelgawad, M.A.; Wu, J.; Mo, X.; Gomha, S.M.; Aly, A.A.; Bräse, S. Recent progress and potential biomedical applications of electrospun nanofibers in regeneration of tissues and organs. Polymers 2022, 14, 1508. [Google Scholar] [CrossRef]
- Attia, N.F.; Eid, A.M.; Soliman, M.A.; Nagy, M. Exfoliation and decoration of graphene sheets with silver nanoparticles and their antibacterial properties. J. Polym. Environ. 2018, 26, 1072–1077. [Google Scholar] [CrossRef]
- Ahmad, R.; Bhat, K.S.; Ahn, M.-S.; Hahn, Y.-B. Fabrication of a robust and highly sensitive nitrate biosensor based on directly grown zinc oxide nanorods on a silver electrode. New J. Chem. 2017, 41, 10992–10997. [Google Scholar] [CrossRef]
- Attia, N.F.; Abd El-Monaem, E.M.; El-Aqapa, H.G.; Elashery, S.E.; Eltaweil, A.S.; El Kady, M.; Khalifa, S.A.; Hawash, H.B.; El-Seedi, H.R. Iron oxide nanoparticles and their pharmaceutical applications. Appl. Surf. Sci. Adv. 2022, 11, 100284. [Google Scholar] [CrossRef]
- Salavagione, H.J.; Martínez, G.; Gómez, M.A. Synthesis of poly(vinyl alcohol)/reduced graphite oxide nanocomposites with improved thermal and electrical properties. J. Mater. Chem. 2009, 19, 5027–5032. [Google Scholar] [CrossRef]
- Zhao, X.; Zhang, Q.; Chen, D.; Lu, P. Erratum: Enhanced mechanical properties of graphene-based poly(vinyl alcohol) composites (Macromolecules (2010) 43 (2357–2363)). Macromolecules 2011, 44, 2392. [Google Scholar] [CrossRef]
- Iravani, S.; Zarepour, A.; Zare, E.N.; Makvandi, P.; Khosravi, A.; Zarrabi, A. Synergistic advancements: Exploring MXene/graphene oxide and MXene/reduced graphene oxide composites for next-generation applications. FlatChem 2024, 48, 100759. [Google Scholar] [CrossRef]
- Zare, I.; Mirshafiei, M.; Kheilnezhad, B.; Far, B.F.; Hassanpour, M.; Pishbin, E.; Vaghefi, S.S.E.; Yazdian, F.; Rashedi, H.; Hasan, A. Hydrogel-integrated graphene superstructures for tissue engineering: From periodontal to neural regeneration. Carbon 2024, 223, 118970. [Google Scholar] [CrossRef]
- Rana, K.; Kaur, H.; Singh, N.; Sithole, T.; Siwal, S.S. Graphene-based materials: Unravelling its impact in wastewater treatment for sustainable environments. Next Mater. 2024, 3, 100107. [Google Scholar] [CrossRef]
- Zhu, W.; Cheng, Y.; Wang, C.; Pinna, N.; Lu, X. Transition metal sulfides meet electrospinning: Versatile synthesis, distinct properties and prospective applications. Nanoscale 2021, 13, 9112–9146. [Google Scholar] [CrossRef]
- Ansari, S.A.M.K.; Ficiarà, E.; Ruffinatti, F.A.; Stura, I.; Argenziano, M.; Abollino, O.; Cavalli, R.; Guiot, C.; D’Agata, F. Magnetic iron oxide nanoparticles: Synthesis, characterization and functionalization for biomedical applications in the central nervous system. Materials 2019, 12, 465. [Google Scholar] [CrossRef]
- Lei, M.; Tang, L.; Du, H.; Peng, L.; Tie, B.; Williams, P.N.; Sun, G. Safety assessment and application of iron and manganese ore tailings for the remediation of As-contaminated soil. Process Saf. Environ. Prot. 2019, 125, 334–341. [Google Scholar] [CrossRef]
- Li, M.; Kuang, S.; Kang, Y.; Ma, H.; Dong, J.; Guo, Z. Recent advances in application of iron-manganese oxide nanomaterials for removal of heavy metals in the aquatic environment. Sci. Total Environ. 2022, 819, 153157. [Google Scholar] [CrossRef]
- Barhoum, A.; Pal, K.; Rahier, H.; Uludag, H.; Kim, I.S.; Bechelany, M. Nanofibers as new-generation materials: From spinning and nano-spinning fabrication techniques to emerging applications. Appl. Mater. Today 2019, 17, 1–35. [Google Scholar] [CrossRef]
- Ghajarieh, A.; Habibi, S.; Talebian, A. Biomedical applications of nanofibers. Russ. J. Appl. Chem. 2021, 94, 847–872. [Google Scholar] [CrossRef]
- Prabhu, P. Nanofibers for medical diagnosis and therapy. Handb. Nanofibers 2019, 831–867. [Google Scholar]
- Zaaba, N.; Foo, K.; Hashim, U.; Tan, S.; Liu, W.-W.; Voon, C. Synthesis of graphene oxide using modified hummers method: Solvent influence. Procedia Eng. 2017, 184, 469–477. [Google Scholar] [CrossRef]
- Kalil, H.; Maher, S.; Bose, T.; Bayachou, M. Manganese oxide/hemin-functionalized graphene as a platform for peroxynitrite sensing. J. Electrochem. Soc. 2018, 165, G3133. [Google Scholar] [CrossRef]
- Gomaa, I.; Emam, M.H.; Wassel, A.R.; Ashraf, K.; Hussan, S.; Kalil, H.; Bayachou, M.; Ibrahim, M.A. Microspheres with 2D rGO/alginate matrix for unusual prolonged release of cefotaxime. Nanomaterials 2023, 13, 1527. [Google Scholar] [CrossRef]
- Vivekanandan, J.; Vijaya Prasath, G.; Selvamurugan, M.; Usha, K.; Ravi, G. Hydrothermal synthesis of Fe2O3 nanoparticles and their electrochemical application. J. Mater. Sci. Mater. Electron. 2024, 35, 230. [Google Scholar] [CrossRef]
- Choudhury, B.J.; Moholkar, V.S. Ultrasound-assisted facile one-pot synthesis of ternary MWCNT/MnO2/rGO nanocomposite for high performance supercapacitors with commercial-level mass loadings. Ultrason. Sonochem. 2022, 82, 105896. [Google Scholar] [CrossRef]
- Drew, W.L.; Barry, A.; O’Toole, R.; Sherris, J.C. Reliability of the Kirby-Bauer disc diffusion method for detecting methicillin-resistant strains of Staphylococcus aureus. Appl. Microbiol. 1972, 24, 240–247. [Google Scholar] [CrossRef]
- Vignesh, R.; Sivakumar, R.; Sanjeeviraja, C. Phase tuning of nebulized spray deposited manganese oxide thin films by the effect of annealing temperature and their linear and non-linear optical parameters. Optik 2022, 254, 168687. [Google Scholar] [CrossRef]
- Alagar, S.; Madhuvilakku, R.; Mariappan, R.; Piraman, S. Nano-architectured porous Mn2O3 spheres/cubes vs. rGO for asymmetric supercapacitors applications in novel solid-state electrolyte. J. Power Sources 2019, 441, 227181. [Google Scholar] [CrossRef]
- Mumtaz, M.; Mumtaz, A.; Nasim, F.; Sajid, M. Capacity Augmentation Strategy in α-Fe2O3 Nanoparticles Through Multifaceted Structural and Electrochemical Analyses. Mater. Chem. Phys. 2024, 329, 130035. [Google Scholar] [CrossRef]
- Naik, Y.V.; Kariduraganavar, M.Y.; Srinivasa, H.T.; Siddagangaiah, P.B.; Naik, R. Super capacitive electrode performance analysis of facile synthesized α-Fe2O3 aerogel and its nanocomposite with in-situ formed polyaniline (α-Fe2O3/PANI). J. Alloys Compd. 2024, 1004, 175820. [Google Scholar] [CrossRef]
- Nalbandian, M.J.; Zhang, M.; Sanchez, J.; Choa, Y.-H.; Nam, J.; Cwiertny, D.M.; Myung, N.V. Synthesis and optimization of Fe2O3 nanofibers for chromate adsorption from contaminated water sources. Chemosphere 2016, 144, 975–981. [Google Scholar] [CrossRef] [PubMed]
- Berenjian, A.; Maleknia, L.; Fard, G.C.; Almasian, A. Mesoporous carboxylated Mn2O3 nanofibers: Synthesis, characterization and dye removal property. J. Taiwan Inst. Chem. Eng. 2018, 86, 57–72. [Google Scholar] [CrossRef]
- Ahmad, J.; Majid, K. Improved thermal stability metal oxide/GO-based hybrid materials for enhanced Anti-inflammatory and Antioxidant activity. Polym. Bull. 2021, 78, 3889–3911. [Google Scholar] [CrossRef]
- Amiri, A.; Mirzaei, M.; Derakhshanrad, S. A nanohybrid composed of polyoxotungstate and graphene oxide for dispersive micro solid-phase extraction of non-steroidal anti-inflammatory drugs prior to their quantitation by HPLC. Microchim. Acta 2019, 186, 534. [Google Scholar] [CrossRef]
- Shoshin, D.E.; Sizova, E.A.; Kamirova, A.M. Morphological changes and luminescence of Escherichia coli in contact with Mn2O3 and Co3O4 ultrafine particles as components of a mineral feed additive. Vet. World 2024, 17, 1880. [Google Scholar] [CrossRef]
- Alangari, A.; Alqahtani, M.S.; Shahid, M.; Syed, R.; Goel, M.; Lakshmipathy, R.; Kaur, K. Green synthesis of FeO nanoparticles from coffee and its application for antibacterial, antifungal, and anti-oxidation activity. Green Process. Synth. 2024, 13, 20230268. [Google Scholar] [CrossRef]
- Ansari, N.; Tripathi, A.; Ameen, S.; Shaheer Akhtar, M.; Jabeen, F.; Rahman Khan, A.; Luqman, M.; Rahman, Q.I. Green Synthesis of Nanomaterials: Properties and Their Potential Applications. Sci. Adv. Mater. 2024, 16, 837–854. [Google Scholar] [CrossRef]
- Sahoo, H.; Sahoo, J.K. Iron Oxide-Based Nanocomposites and Nanoenzymes: Fundamentals and Applications; Springer Nature: Berlin/Heidelberg, Germany, 2024. [Google Scholar]
Disclaimer/Publisher’s Note: The statements, opinions and data contained in all publications are solely those of the individual author(s) and contributor(s) and not of MDPI and/or the editor(s). MDPI and/or the editor(s) disclaim responsibility for any injury to people or property resulting from any ideas, methods, instructions or products referred to in the content. |
© 2024 by the authors. Licensee MDPI, Basel, Switzerland. This article is an open access article distributed under the terms and conditions of the Creative Commons Attribution (CC BY) license (https://creativecommons.org/licenses/by/4.0/).